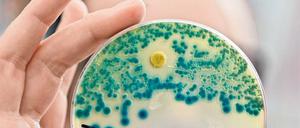
Tückisch. Über die Folgen von Antibiotika-Resistenzen gibt es keine seriösen Hochrechnungen.

Empathie und Einfühlungsvermögen sind ein zentraler Teil des ärztlichen Denkens und Handelns. Deswegen sollten sie ein Herzstück der Ausbildung sein. Ein Gastbeitrag.

Empathie und Einfühlungsvermögen sind ein zentraler Teil des ärztlichen Denkens und Handelns. Deswegen sollten sie ein Herzstück der Ausbildung sein. Ein Gastbeitrag.

Typische Krankheitszeichen sind Kribbeln und Sehstörungen. Nun soll ein neuer Wirkstoff die aggressive Form des Nervenleidens Multiple Sklerose erstmals in Schach halten.

Bei Migräneattacken können die Betroffenen oft nichts mehr tun, als sich im Bett zu verkriechen. Eine neue Therapie gegen den Kopfschmerz soll nun helfen.

Berlin hat bundesweit niedrigste Sterblichkeit an Herz-Kreislauf-Krankheiten - das zeigt der neue Deutsche Herzbericht.

Studienbewerber für das Fach Medizin müssen oft einen Einser-Schnitt mitbringen, um den NC zu überwinden - oder viele Jahre warten.

Der Bundestag gibt Cannabis einstimmig als Medizin frei – aber die Droge ist kein Wundermittel.

Eine US-Amerikanerin brach sich in Indien ihr Bein, die Wunde infizierte sich. Der Keim war gegen alle in den USA erhältlichen Antibiotika resistent. Niemand konnte ihr helfen.

Geschäftsgeheimnisse und große Hoffnung, Schlamperei und Geld: 2016 starben allein bei Medikamententests der Firmen Bial und Juno sechs Menschen. Was lief schief und welche Lehren wurden daraus gezogen?

Beim Mammographie-Screening kommt es zu Überdiagnosen und Übertherapie. Die Abhilfe ist bislang schwierig.

Präzision ist nicht immer optimale Strategie im Kampf gegen Krebs, sagt der Onkologe Ross Cagan. Er sucht mithilfe von Taufliegen nach der bestmöglichen Behandlung.

Ein dickes Tabu: SPD-Chef Gabriel hat sich den Magen verkleinern lassen - offiziell, weil er zuckerkrank ist. Denn starkes Übergewicht gilt als Charakterschwäche.

Nach dem Tod zweier Studentinnen wollen sich tausende Italiener gegen Meningitis impfen lassen – dabei gibt es gar keine Häufung von Hirnhautentzündungen, nur viele Gerüchte

Auch wer sein Sportpensum in ein oder zwei Trainingseinheiten absolviert, senkt damit sein Sterberisiko.

Berlin soll Hauptstadt der Alternativen für Tierversuche werden. Aber nicht jeden Test kann man in der medizinischen Forschung vermeiden.

An Silvester schnellt die Feinstaubbelastung in den Städten nach oben. Doch während sich der Dunst in Berlin bald verteilte, blieb München unter einer Giftglocke.

Felix Lorenz will das Immunsystem im Kampf gegen den Krebs stärken.

Therapie aus dem Meer: Ein neuartiges Verfahren ermöglicht die schonende Behandlung von Prostatakrebs im Frühstadium.

In Großbritannien ist es nun ausdrücklich erlaubt, Drei-Eltern-Babys auszutragen – wenn es dafür gute Gründe gibt. Eine Zusammenfassung.

Das heimtückische Attentat auf einem Berliner Weihnachtsmarkt stellte für die Notfallversorgung in der Hauptstadt einen historischen Ernstfall dar, schreibt unser Gastautor - und sieht Nachholbedarf.

Wenn die Mutter während der Schwangerschaft mit Zika infiziert war, ist die Mikrozephalie nur eine Folge unter vielen. Vor allem aber schädigt Zika das Baby-Hirn nach der Geburt weiter.
Multiresistente Keime sind eine große Gefahr – doch wie viele Leben sie in Zukunft tatsächlich kosten werden, kann niemand prognostizieren.

Als erstes Land weltweit lässt Großbritannien zu, dass Babys mit dem Erbgut dreier Menschen ausgetragen werden - zumindest in klinischen Studien. Die Mitochondrien-Ersatz-Therapie soll schwere Erbleiden verhindern.

Wer das Erbgut verstehen will, muss seine 3-D-Struktur beachten, sagt der Genetiker Daniel Ibrahim.

Berliner Forscher haben einen Mechanismus entdeckt, der den überempfindlichen Tastsinn bei Patienten dämpfen kann.

Wenn die Brust schmerzt, ist nicht immer gleich ein Herzkatheter nötig. Bei Patienten mit niedrigem Risiko reicht mitunter eine CT-Aufnahme.

Die mangelhafte Finanzierung gefährdet die Fortschritte im Kampf gegen Malaria, warnt die WHO. Aufgrund von Resistenzen müssen zudem neue Wirkstoffe entwickelt werden.

In Pflegeheimen werden verwirrte Bewohner oft hinter Bettgitter gesteckt oder angegurtet. Ob sie dieser Freiheitsentzug wirklich schützt, ist fraglich.

Ob ein Medikament wirkt, hängt mitunter von der Herkunft eines Menschen ab. Die Genetik könnte helfen, meint Eimear Kenny.

Die Pocken gelten als Seuche, die die Menschen seit Urzeiten begleitet hat. Schließlich hatte schon Pharao Ramses entsprechende Narben. Das könnte ein Trugschluss sein.

Das simulierte Denkorgan soll der Medizin helfen, sagt Petra Ritter. Etwa bei der Behandlung von Epilepsie.

Nach dem Tagesspiegel-Beitrag zu Beschimpfungen auf der Rettungsstelle des Urban-Klinikums: Jetzt sagt der Direktor, wie man auf Bedrohungen reagiert.

Beispiel Urban-Krankenhaus: Unfassbare Beleidigungen des Rettungsstellenpersonals sind in Berliner Kliniken an der Tagesordnung, berichtet unser Gastautor.

Kindern mit spinaler Muskelatrophie (SMA) konnten Ärzte bisher kaum helfen. Nun gibt es ein erstes experimentelles Mittel, das den Verlauf des Leidens bremst. Heilen kann es den Gendefekt nicht.

Lange galt, dass ein Antibiotikum über längere Zeit genommen werden muss. Auch dann, wenn man wieder gesund ist. Das ist überholt.

Chemo ja oder nein? Diese Entscheidung aufgrund eines Genexpressionstests zu treffen, ist zu unsicher für Brustkrebs-Patientinnen, meint das IQWiG - und befeuert damit erneut den Streit.

Auch der Mediziner und Comedian ist nicht vor Schmerzen im Knie gefeit. Hier erzählt er, was er als Patient auf seiner Odyssee von Arzt zu Arzt erlebt hat.

Es gibt große Fortschritte in der Therapie von HIV– aber längst nicht alle Betroffenen profitieren davon. Auch bei der Bekämpfung von Hepatitis gibt es Nachholbedarf,

Nicht mehr zu essen und zu trinken, kann eine selbstbestimmte Art des Sterbens sein. Doch das erfordert eine gute Begleitung.
Auch dieser Ansatz hat nicht zum Ziel geführt. Ein Alzheimer-Medikament mit dem Wirkstoff Solanezumab wird es nicht geben.

Laut einer neuen Studie ist das Risiko, an Demenz zu erkranken, um fast ein Viertel gesunken. Und: Dicke erkranken seltener als Dünne.
öffnet in neuem Tab oder Fenster